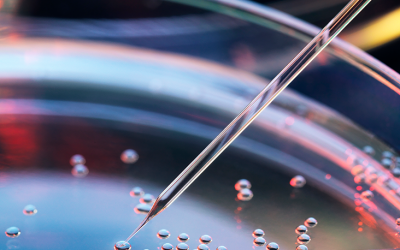
Vertex Type 1 Diabetes Research Stirs Hope for Stem Cell-Based ‘Cure’

The HoPE Blog
Michelle Obama Announces New Netflix Children’s Show Focused On Healthy Eating
Former first lady Michelle Obama announced Tuesday she is launching a new children's show on...
Dettol Liquid Hand wash, Original – 750 ml : Amazon.in: Health & Personal Care
Loading recommendations for you Item is in your Cart There was a problem adding this item to Cart....
FDA Issues New Guidelines on Salt in Foods
Experts say a reduction of sodium in our foods may be difficult to accomplish since salt is used to enhance flavor as well as preserve food longerThis content was originally published here.
What to Say to a Friend Questioning Their Gender Identity
You may be eager to be an ally to a friend, or you may be caught off-guard and unsure what to do next. Here are some expert tips on what to say and do — and what to avoid.Do: Keep the coming out conversation positiveFerraiolo says he didn’t choose to have gender...
Vertex Type 1 Diabetes Research Stirs Hope for Stem Cell-Based ‘Cure’
The media hype around Vertex’s initial results is not without controversy. Those of us who’ve lived with this condition for years are naturally skeptical about any talk of a possible “cure” — since we’ve heard it so many times before.Regarding Vertex, many in the...
Helping Others Can Make You Happier as You Age
Share on PinterestResearchers say older adults can be happier by doing things for others. Chalit Saphaphak/Stocksy UnitedDoes the fountain of youth and happiness flow with charitable giving and doing for others?A newly published scientific study hints that it...
Product Review: Tandem Diabetes Control-IQ
The system is cleared for kids as young as 6 years old, and adults with either type 1 or type 2 diabetes. Here is a look at the basic features on this system. Touchscreen and sleek designThe Tandem t:slim pump is the first to feature a touchscreen, giving it an...
New Diabetes Technology Coming in 2022
Minimed 780 and Guardian 4 CGM sensorMany are also waiting for Medtronic’s next-generation combo insulin pump and CGM sensor system, which will be the 780G — also known as the Advanced Hybrid Closed Loop (AHCL) system. This system will expand upon the foundation of...
HoPE Online Shop
CLICK HERE
AS SEEN ON
Address
Unit 2905 King Palace Plaza, 52A Sha Tsui Road, Tsuen Wan, NT, Hong Kong
Hours
Mon-Friday
9am to 6pm
GMT +8
Phone
(852) 3950 5999